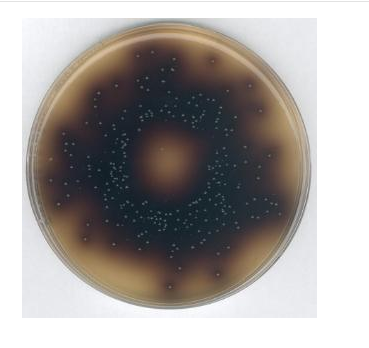

Code: 1.07228.5000
Merck Life Science Private Limited - Offering Granu Cult Buffered Peptone Water, Peptone Water for microbiology, Alkaline Peptone Water (APW), Buffered ...
per 5KG
Loading...
Dehydrated media are used for a wide variety of applications. To minimise the risks associated with powdered culture media, the majority of Merck's dehydrated culture media is produced in granular form. Merck uses ingredients of non animal origin to minimise the potential risk of transmissible spongiform encephalitis (TSE). When there is no alternative, only ingredients which are recommended by EDQM, and belonging to TSE category B or C are used. This ensures that the product is of the highest quality and in compliance with the standards for food control, microbiological testing on finished products and starting materials, and quality control in the pharmaceuticals and cosmetics industries. Custom-made media can be prepared to meet individual customer specifications. The formulation is kept confidential via a Non Disclosure Agreement. Please enquire for further details. Advantages of granulated Merck media.
Substantially less dust is generated during handling, reducing the risks of sensitisation and the intake of toxic substances
Simple to use as the granules have good wetting properties, which speeds up the suspension and dissolution process and avoids the formation of hard to dissolve clumps
Homogeneous distribution of ingredients in the pack is guaranteed even after prolonged storage, so there are no adverse segregation effects
Economical, because there is no need to purchase and handle additional expensive supplements, whenever possible the base medium contains the selective components
Safe, because the animal-derived media are produced from BSE low risk (Cat III and IV) ingredients
Certifications: Compositions comply with standards such as ISO, AFNOR, APHA, AOAC, FDA-BAM, USDA-FSIS, EP and USP.